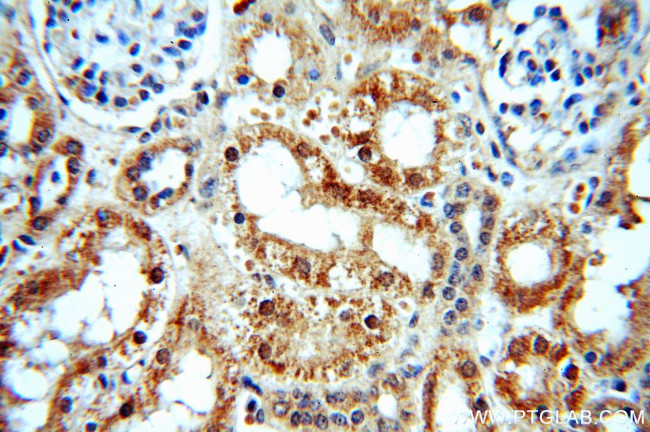
PKNOX2 Antibody in Immunohistochemistry (Paraffin) (IHC (P))

Search
Proteintech
PKNOX2 Polyclonal Antibody
{{$productOrderCtrl.translations['antibody.pdp.commerceCard.promotion.promotions']}}
{{$productOrderCtrl.translations['antibody.pdp.commerceCard.promotion.viewpromo']}}
{{$productOrderCtrl.translations['antibody.pdp.commerceCard.promotion.promocode']}}: {{promo.promoCode}} {{promo.promoTitle}} {{promo.promoDescription}}. {{$productOrderCtrl.translations['antibody.pdp.commerceCard.promotion.learnmore']}}
产品信息
20352-1-AP
种属反应
宿主/亚型
分类
类型
抗原
偶联物
形式
浓度
规格
纯化类型
保存液
内含物
保存条件
运输条件
产品详细信息
Immunogen sequence: MLDASNPDP APKAKKIKSQ HRPTQRFWPN SIAAGVLQQQ GGAPGTNPDG SINLDNLQSL SSDSATMAMQ QAMMAAHDDS LDGTEEEDED EMEEEEEELE EEVDELQTTN VSDLGLEHSD SLE (350-471 aa encoded by BC045626)
靶标信息
PREP-2 (Pbx-regulating protein-2), also known as PBX/knotted 1 homeobox 2 or PKNOX2, is a widely expressed protein belonging to the TALE (three amino acid loop extension)/MEIS family. PREP-2 is a DNA-binding protein that forms stable complexes with Pbx proteins. It is highly homologous to the related protein PREP-1, but displays a more restricted tissue distribution and a higher DNA-dissociation rate. Like PREP-1, PREP-2 forms a heterodimer with Pbx 1. The PREP-2-Pbx 1 dimer is relocated to the nucleus where it associates with HoxB1 to form a ternary complex. In contrast with PREP-1, which acts to increase transcriptional activation in this ternary complex, PREP-2 leads to a slight decrease in transcriptional activity of the ternary complex. Multiple isoforms exist for PREP-2, localizing to the nucleus or cytoplasm. Cytoplasmic isoforms are believed to colocalize with F-actin, G-actin and tubulin/microtubules.
仅用于科研。不用于诊断过程。未经明确授权不得转售。
生物信息学
蛋白别名: homeobox protein Meis2-like; Homeobox protein PKNOX2; Homeobox protein PREP-2; homeodomain containing transcription factor PREP2; PBX/knotted homeobox 2; unnamed protein product
基因别名: D230005H23Rik; PKNOX2; PREP2
UniProt ID: (Human) Q96KN3, (Mouse) Q8BG99
Entrez Gene ID: (Human) 63876, (Mouse) 208076, (Rat) 680549